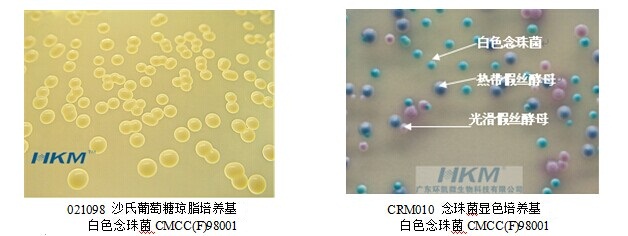
沙氏葡萄糖瓊脂培養(yǎng)基 沙氏葡萄糖瓊脂培養(yǎng)基

白色念珠菌(Candida albicans)又名白假絲酵母菌(Saccharomyces albicans)屬假絲酵母菌屬(Saccharomyces )。在SDA 上培養(yǎng)2 日后涂片鏡檢,呈革蘭陽性(如圖1),但著色不均,菌體呈卵圓形(2. 5~4μm )、薄壁;而在玉米粉一吐溫80 培養(yǎng)基上培養(yǎng)3 日后涂片,可見頂端圓形的厚壁抱子(如圖2) 。白色念珠菌以出芽方式繁殖,在適宜的培養(yǎng)基上有芽生孢子及假菌絲生長,在假菌絲間其末端形成厚膜孢子。白色念珠菌是條件致病菌,是醫(yī)學(xué)全身性真菌感染病的重要組成之一,一旦感染,??梢鹦膬?nèi)膜炎、肺炎、尿布瘆、鵝口瘡、陰道炎、腦膜炎及敗血癥等。
白色念珠菌廣泛分布于土壤、水和空氣中,目前國內(nèi)外的藥品、食品標(biāo)準(zhǔn)巳把白色念珠菌作為微生物檢驗(yàn)中酵母菌的代表菌,因此有些藥品依據(jù)給藥途徑和劑型將白色念珠菌作為控制菌是非常必要的。
白色念珠菌是雙相型真菌,有酵母相和菌絲相兩種形態(tài),在一定條件下,酵母相可轉(zhuǎn)變?yōu)榫z相。酵母相幾乎沒有致病力,菌絲相有較強(qiáng)的致病力和毒力。芽管是白色念珠菌從酵母相向菌絲相轉(zhuǎn)變的最初階段,芽管繼續(xù)發(fā)展形成菌絲。芽管形成與白色念珠菌的致病力密切相關(guān)。芽管試驗(yàn)是白色念珠菌在有營養(yǎng)的液體環(huán)境中35?37°C培養(yǎng)1~3h,可從酵母細(xì)胞生出芽管(類似于體內(nèi)狀態(tài)),因此,芽管試驗(yàn)是快速、可靠鑒定白色念珠菌的傳統(tǒng)方法之一。

圖1:制藥業(yè)白色念珠菌檢測流程

HKM制藥業(yè)白色念珠菌檢測全套培養(yǎng)基